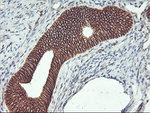
Beta-catenin Antibody in Immunohistochemistry (Paraffin) (IHC (P))

Search
OriGene
Beta-catenin Monoclonal Antibody (OTI1H10), TrueMAB™
{{$productOrderCtrl.translations['antibody.pdp.commerceCard.promotion.promotions']}}
{{$productOrderCtrl.translations['antibody.pdp.commerceCard.promotion.viewpromo']}}
{{$productOrderCtrl.translations['antibody.pdp.commerceCard.promotion.promocode']}}: {{promo.promoCode}} {{promo.promoTitle}} {{promo.promoDescription}}. {{$productOrderCtrl.translations['antibody.pdp.commerceCard.promotion.learnmore']}}
产品信息
CF502300
种属反应
宿主/亚型
分类
类型
克隆号
抗原
偶联物
形式
浓度
纯化类型
保存液
内含物
保存条件
运输条件
产品详细信息
For reconstitution, we recommend adding 100 µL distilled water to a final antibody concentration of about 1 mg/mL. To use this carrier-free antibody for conjugation experiments, we strongly recommend performing another round of desalting. (Zeba Spin Desalting Columns, 7KMWCO, 0.5 mL, Product # 89882)
靶标信息
Beta-catenin, an adherens junction (AJ) protein, was originally identified as a component of cell-cell adhesion structures. AJs are necessary for the creation and maintenance of epithelial cell layers by regulating cell growth and adhesion between cells. Beta-catenin interacts with the cytoplasmic domain of E-cadherin and links E-cadherin to alpha-catenin, which in turn mediates anchorage of the E-cadherin complex to the cortical actin cytoskeleton. Studies show that Beta-catenin also binds to another cytoskeletal complex containing the adenomatous polyposis coli protein and microtubules, and interacts with several signaling pathways that include tyrosine kinases, phosphatases and Wnt/Wingless. The interplay between beta-catenin, cytoskeletal complexes and signaling pathways may regulate morphogenesis. Beta-catenin is expressed in several hair follicle cell types, basal and peripheral matrix cells, and cells of the outer and inner root sheats. A pathological role of beta-catenin has been identified in pilomatrixoma (PTR), medulloblastoma (MDB), colorectal cancer (CRC), ovarian cancer, and tumor development. In the nucleus, beta-catenin serves to co activate a family of Lef/Tcf transcription factors that stimulate transcription of target genes including those encoding cyclin D and c-myc that promote cell proliferation. The influence on cell proliferation is the molecular basis for the role of beta-catenin in tumorgenesis, specifically, solid tumors of the breast, colon, liver, lung, gastric, prostate, and skin.
仅用于科研。不用于诊断过程。未经明确授权不得转售。
篇参考文献 (0)
生物信息学
蛋白别名: Bcatenin; beta 1 88kDa; Beta-catenin; Betacatenin; C20orf33; Cadherin associated protein; catenin; catenin (cadherin-associated protein), beta 1; catenin (cadherin-associated protein), beta 1, 88kDa; Catenin b 1; Catenin b1; Catenin beta-1; Catenin beta1; Catenin β 1; Catenin β1; CTNB1; dJ633O20.1; DKFZp686D02253; FLJ25606; FLJ37923; NAP; NYD-SP19; OTTHUMP00000209289; P14L; PP8304; RP5-1118M15.1; β catenin; βcatenin
基因别名: armadillo; Bfc; Catnb; CTNNB; CTNNB1; Mesc; MRD19; OK/SW-cl.35; PRO2286
UniProt ID: (Human) P35222, (Mouse) Q02248
Entrez Gene ID: (Human) 1499, (Mouse) 12387